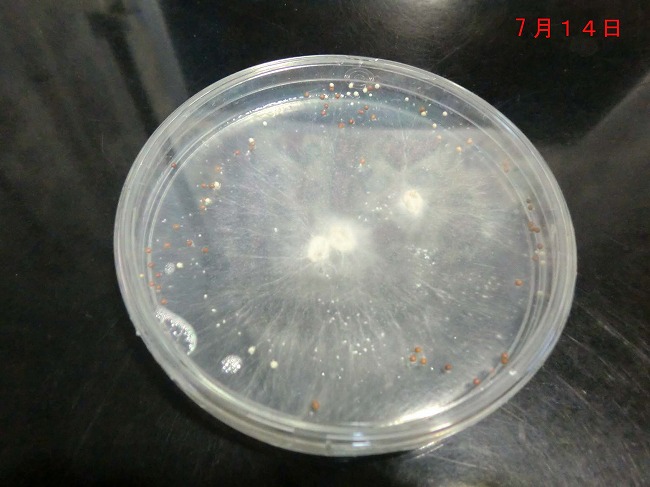

| こちらでは、タマリュウの一般的な病害をご紹介致します。 次の事例を見てください。 |
| □ 症状:葉が変色し、それが拡がっているように見える。 |
 もう少し近寄ってみてみましょう。 根元が茶色く変色しているように見えます。 |
.jpg) |
この茶色くなった葉を採取し、持ち帰ります。 そして、事務所の応接室(実験室へと変る)にて、病原菌の培養をして菌の同定を試みます。 |
.jpg) |
数日すると、培地の中に白い菌糸が拡がってきました。 .jpg) 裏面はこのような状態でした。 (解る人には、この時点で大体の見当が付きます。) |
.jpg) |
顕微鏡で詳細を見てみましょう! この写真は、約40倍です。 .jpg) |
菌糸がキレイに伸びています。 どこかに胞子があるはずです。 それを探します。 .jpg) ありましたね。 こいつですね。 これで病原菌の ’属’ までが判明しました。 そうなると、これに有効な ’殺菌剤’ もおのずと決定されるわけです。 つまり どんな農薬を購入するべきなのかが判明します。 (※ 博職家の方へ:厳密には、これらの菌糸を再培用し健全な植物体に接種し、病害を再現しなければならない事は理解しています。(コッホの法則) しかし、この病気はすでに病害として登録がある為(植物病理学会)、 一般の管理においては、そこまで必要ないと判断しています。) |
.jpg) |
ちなみにですが、このような(↓) 結果になることもあります。 これは原因する菌が全く別物です。 人に例えますと、インフルエンザと風邪。 病気の症状は似ていますが、処方する薬も違うでしょう? 風邪をひいて ’タミフル’を飲みませんよね! (^^♪ |